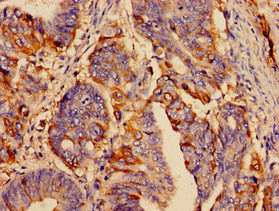

SST Antibody
-
中文名稱:SST兔多克隆抗體
-
貨號:CSB-PA022723OJ01HU
-
規格:¥440
-
圖片:
-
其他:
產品詳情
-
產品名稱:Rabbit anti-Homo sapiens (Human) SST Polyclonal antibody
-
Uniprot No.:
-
基因名:SST
-
別名:Growth hormone release inhibiting factor antibody; Growth hormone release-inhibiting factor antibody; Prepro somatostatin antibody; SMS_HUMAN antibody; SMST antibody; Somatostatin 14 antibody; Somatostatin 28 antibody; Somatostatin-14 antibody; SST antibody
-
宿主:Rabbit
-
反應種屬:Human
-
免疫原:Peptide sequence from Human Somatostatin protein
-
免疫原種屬:Homo sapiens (Human)
-
標記方式:Non-conjugated
-
克隆類型:Polyclonal
-
抗體亞型:IgG
-
純化方式:>95%, Protein G purified
-
濃度:It differs from different batches. Please contact us to confirm it.
-
保存緩沖液:Preservative: 0.03% Proclin 300
Constituents: 50% Glycerol, 0.01M PBS, PH 7.4 -
產品提供形式:Liquid
-
應用范圍:ELISA, IHC
-
推薦稀釋比:
Application Recommended Dilution IHC 1:20-1:200 -
Protocols:
-
儲存條件:Upon receipt, store at -20°C or -80°C. Avoid repeated freeze.
-
貨期:Basically, we can dispatch the products out in 1-3 working days after receiving your orders. Delivery time maybe differs from different purchasing way or location, please kindly consult your local distributors for specific delivery time.
-
用途:For Research Use Only. Not for use in diagnostic or therapeutic procedures.
相關產品
靶點詳情
-
功能:Inhibits the secretion of pituitary hormones, including that of growth hormone/somatotropin (GH1), PRL, ACTH, luteinizing hormone (LH) and TSH. Also impairs ghrelin- and GnRH-stimulated secretion of GH1 and LH; the inhibition of ghrelin-stimulated secretion of GH1 can be further increased by neuronostatin.; May enhance low-glucose-induced glucagon release by pancreatic alpha cells. This effect may be mediated by binding to GPR107 and PKA activation. May regulate cardiac contractile function. May compromise cardiomyocyte viability. In the central nervous system, may impair memory retention and may affect hippocampal excitability. May also have anxiolytic and anorexigenic effects. May play a role in arterial pressure regulation. May inhibit basal, but not ghrelin- or GnRH-stimulated secretion of GH1 or LH, but does not affect the release of other pituitary hormones, including PRL, ACTH, FSH or TSH. Potentiates inhibitory action of somatostatin on ghrelin-stimulated secretion of GH1, but not that on GnRH-stimulated secretion of LH.
-
基因功能參考文獻:
- Temporal changes in levels of circulating SST mirror the temporal changes in the incidence of migraine, particularly in women. The SST2 receptor agonist octreotide has been used with some success in migraine and cluster headache. Authors suggest that the withdrawal of descending tone in SST-containing neurons, might create a false pain signal and hence the headache of migraine. [Review] PMID: 29751998
- By unbiased genome-wide DNA methylation profiling and comprehensive stepwise verification and validation studies using in vitro and patient-derived samples, we identified 3 promising methylation markers (GHSR, SST, and ZIC1) associated with a 3q gain for the detection of cervical (pre)cancer PMID: 28119363
- Somatostatin pancreatic Delta cells (D cells) locations have also been confirmed in animals and human [review]. PMID: 27977627
- Remarkably, the cyclic neuroendocrine peptide somatostatin-14 (SST14) was observed to be the most selectively enriched oligomeric Abeta1-42 binder. PMID: 28650319
- This study demonstrated that expression of somatostatin its colocalization with alpha-synuclein in Amygdala in patient with Parkinson disease. PMID: 28859333
- These results suggest that the poly-T repeat sequence polymorphism in the promoter of the SST gene is associated with significant variations of blood pressure and could modulate the risk of hypertension, particularly among women. PMID: 26818653
- High N-terminal prosomatostatin expression is associated with Cardiovascular Disease and Diabetes. PMID: 27399347
- Data show that 6 of 20 primary pancreatic neuroendocrine tumors (PNETs) had positive staining for multiple hormones gastrin, insulin, glucagon, and somatostatin, and positive expression of 1 or more hormones was found in 9 of 12 nonfunctioning PNETs [NF-PNETs]) patients. PMID: 26684862
- Patients with chronic pancreatitis were found to have a strong immunohistochemical reaction to somatostatin and changes in the distribution of D cells when compared to healthy patients. PMID: 26589890
- Results suggest that DNA methylation may be a proximal mechanism for decreased expression of BDNF, SST, and other BDNF- and GABA-related genes with brain aging and, by extension, for brain disorders in which their expression is decreased PMID: 25881116
- In cancerous colonic mucosa promoter hypermethylation-related SST downregulation may contribute to the uncontrolled cell proliferation. PMID: 25723531
- Aberrant methylation inactivates somatostatin and SSTR1 in head and neck squamous cell carcinoma. PMID: 25734919
- Distribution of peptidergic populations in the human dentate gyrus (somatostatin [SOM-28, SOM-12] and neuropeptide Y [NPY]) during postnatal development. PMID: 24965867
- The aim of the study was to provide knowledge on somatostatin and its action on the body, particularly the pancreas - in physiological and pathological conditions--{REVIEW} PMID: 25156131
- Somatostatin and insulin together are critical paracrine mediators of glucose-inhibited glucagon secretion and function by lowering cAMP/PKA signaling with increasing glucose. PMID: 25406263
- No somatostatin promoter hypermethylation was detected in the Alzheimer neocortex. PMID: 24602981
- Hemostatic effects and safety does not differ significantly between somatostatin and octreotide as adjuvants to endoscopic treatment in patients with acute gastroesophageal variceal bleeding. PMID: 24415445
- Somatostatin neurons contribute differently to spatial integration. PMID: 23825418
- somatostatin limits VEGF release through its interaction with miR-361, indicating that miR-361 participates in the adaptive response of human umbilical vein endothelial cells to hypoxia PMID: 23128854
- Somatostatin interneurons-mediated disinhibition represents an important circuit mechanism for cortical information processing. PMID: 23312523
- Data suggest that SST-14 inhibits secretion from alpha and beta pancreatic cells by activating GIRK (G protein-coupled inwardly-rectifying potassium channel) and inhibiting exocytosis; these effects are mediated by SST receptor 2 in both cell types. PMID: 22932785
- Investigation of the healthy human pylorus shows characteristic distribution of cells that react with antisera to gastrin and somatostatin. PMID: 22532184
- PDZ domain-containing 1 (PDZK1) protein regulates phospholipase C-beta3 (PLC-beta3)-specific activation of somatostatin by forming a ternary complex with PLC-beta3 and somatostatin receptors. PMID: 22528496
- role played by somatostatin in preventing Abeta accumulation by partially restoring IDE activity PMID: 22509294
- Somatostatin neurons hyperpolarized and reduced action potential firing in response to both passive and active whisker sensing, in contrast with all other recorded types of nearby neurons in transgenic mice. PMID: 22366760
- Alterations in SST signaling and/or SST-bearing GABA neurons may represent a critical pathophysiological entity that contributes to singulate cortex dysfunction and that matches to the high female vulnerability to develop major depressive disorder. PMID: 21232602
- somatostatin inhibits the neuropeptide Y response to hypoglycemia PMID: 21640760
- somatostatin suppresses GH activity in peripheral tissues PMID: 21632809
- Synchronous firing strength correlates with, and is dependent on, unidirectional or reciprocal GABAergic synapses between electrically coupled fast-spiking and somatostatin-containing inhibitory interneuron subtypes in transgenic mice. PMID: 21368047
- SST, presumably via SSTR3/MUPP1, regulates tight junction permeability in cultured keratinocytes PMID: 20629740
- Mean value of serum somatostatin at baseline was significantly increased in Parkinson's disease patients compared with the control group (P < 0.01) PMID: 20055772
- Data show an increasing tendency in the expressions of GAS and SS in children with chronic gastritis and duodenal ulcer. PMID: 17229384
- Increased MCT1 association with CD147 at the apical membrane in response to somatostatin (SST) is p38 MAP kinase dependent and underlies the stimulatory effects of SST on butyrate uptake in human intestinal epithelial cells. PMID: 20501436
- somatostatin decreases in Alzheimer's disease and its expression may be linked with Abeta deposition PMID: 19559700
- down-regulated KLF4, CHGA, GPX3, SST and LIPF, together with up-regulated SERPINH1, THY1 and INHBA is an 8-gene signature for gastric cancer PMID: 20043075
- Our results supported the notion that the C allele of the rs4988514 polymorphism may increase the risk for AD in the Chinese population and possibly have additive effect with the APOE epsilon4 allele. PMID: 19733630
- A critical analysis is made of the structure and physiology of SST and its receptors, and the possible role it plays in cell proliferation in animal models and the treatment of human tumors. PMID: 11753230
- The somatostatin-28 (S-28) NPAMAP peptide sequence constitutes an accurate alpha-helix nucleation motif allowing for the generation of equal amounts of S-28 and somatostatin-14 from their common precursor in cultured cells. PMID: 11814357
- Somatostatin acts as a selective chemoattractant for immature hematopoietic cells PMID: 11823046
- Structural motifs in the somatostatin precursor PMID: 11860030
- Somatostatin modulates G-CSF-induced but not interleukin-3-induced proliferative responses in myeloid 32D cells via activation of somatostatin receptor subtype 2. PMID: 11920268
- present in human colorectal adenocarcinomas and liver metastases PMID: 12174892
- somatostatin receptor 2 mRNA was selectively expressed, somatostatin mRNA was not detectable, and cortistatin mRNA was expressed in all samples of monocytes monocyte-derived macrophages, and dendritic cells in basal and lipopolysaccharide-activated state PMID: 12684217
- somatostatin has a role in inhibiting ERK 1/2 signaling and the PI3-K pathway via the inhibition of Rac in SHSY5Y cells PMID: 12902325
- Fasting but not postprandial hypersomatostatinemia, mainly due to an increase in SS-14, characterizes acromegaly. Excess GH/IGF-I could be a causal factor in somatostatin hypersecretion. PMID: 12952361
- Reduced ghrelin, impaired growth hormone(GH) response to GHRH by excess FFA, and increased somatostatin tone contribute to reduced GH secretion in patients with HIV-lipodystrophy. PMID: 14559725
- High concentration of somatostatin (SST) in respiratory centers of fetal brainstems correlates with its involvement in the inhibition of intrauterine breathing. PMID: 15266779
- SST acts both centrally and peripherally to control the GH-IGF-I axis. PMID: 15286801
- certain bioactive peptides such as somatostatin and substance P directly interact with human P-glycoprotein as endogenous substrates for P-glycoprotein-mediated transport PMID: 15358539
- human visceral adipose tissue secretes SRIF during inflammation and sepsis PMID: 15472172
顯示更多
收起更多
-
亞細胞定位:Secreted.
-
蛋白家族:Somatostatin family
-
數據庫鏈接:
Most popular with customers
-
-
YWHAB Recombinant Monoclonal Antibody
Applications: ELISA, WB, IHC, IF, FC
Species Reactivity: Human, Mouse, Rat
-
Phospho-YAP1 (S127) Recombinant Monoclonal Antibody
Applications: ELISA, WB, IHC
Species Reactivity: Human
-
-
-
-
-